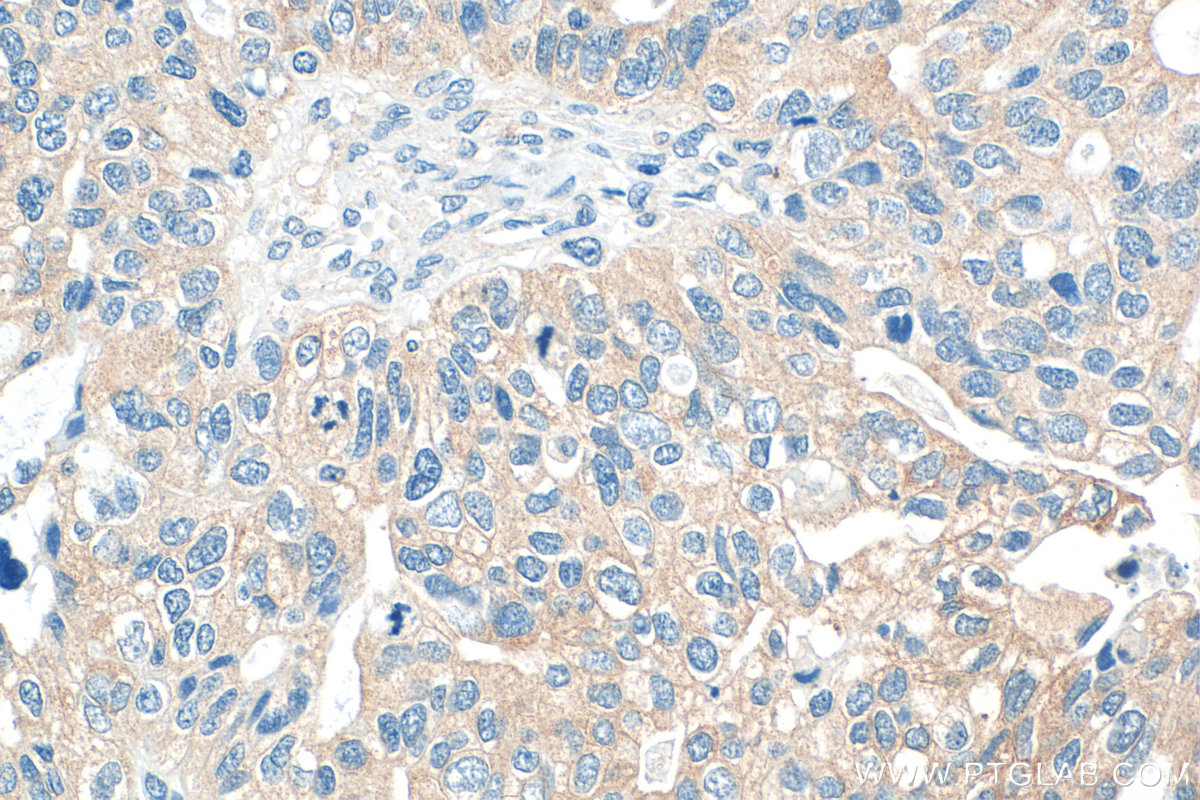
Immunohistochemical analysis of paraffin-embedded human ovary tumor tissue slide using 24017-1-AP (LIN28B antibody) at dilution of 1:200 (under 40x lens). Heat mediated antigen retrieval with Tris-EDTA buffer (pH 9.0). IHC staining of human ovary tumor using 24017-1-AP

验证数据展示
经过测试的应用
| Positive WB detected in | HEK-293 cells, HepG2 cells, K-562 cells |
| Positive IP detected in | HEK-293 cells |
| Positive IHC detected in | human ovary tumor tissue Note: suggested antigen retrieval with TE buffer pH 9.0; (*) Alternatively, antigen retrieval may be performed with citrate buffer pH 6.0 |
| Positive IF/ICC detected in | NCCIT cells |
推荐稀释比
| 应用 | 推荐稀释比 |
|---|---|
| Western Blot (WB) | WB : 1:500-1:3000 |
| Immunoprecipitation (IP) | IP : 0.5-4.0 ug for 1.0-3.0 mg of total protein lysate |
| Immunohistochemistry (IHC) | IHC : 1:50-1:500 |
| Immunofluorescence (IF)/ICC | IF/ICC : 1:200-1:800 |
| It is recommended that this reagent should be titrated in each testing system to obtain optimal results. | |
| Sample-dependent, Check data in validation data gallery. | |
产品信息
24017-1-AP targets LIN28B in WB, IHC, IF/ICC, IP, ELISA, PLA applications and shows reactivity with human, mouse samples.
| 经测试应用 | WB, IHC, IF/ICC, IP, ELISA Application Description |
| 文献引用应用 | WB, IHC, IF, IP, PLA |
| 经测试反应性 | human, mouse |
| 文献引用反应性 | human, mouse |
| 免疫原 |
CatNo: Ag21241 Product name: Recombinant human LIN28B protein Source: e coli.-derived, PGEX-4T Tag: GST Domain: 94-250 aa of BC137526 Sequence: LESIRVTGPGGSPCLGSERRPKGKTLQKRKPKGDRCYNCGGLDHHAKECSLPPQPKKCHYCQSIMHMVANCPHKNVAQPPASSQGRQEAESQPCTSTLPREVGGGHGCTSPPFPQEARAEISERSGRSPQEASSTKSSIAPEEQSKKGPSVQKRKKT 种属同源性预测 |
| 宿主/亚型 | Rabbit / IgG |
| 抗体类别 | Polyclonal |
| 产品类型 | Antibody |
| 全称 | lin-28 homolog B (C. elegans) |
| 别名 | CSDD2, lin 28 homolog B (C. elegans), Lin 28B, Lin28, Lin-28B |
| 计算分子量 | 250 aa, 27 kDa |
| 观测分子量 | 35 kDa |
| GenBank蛋白编号 | BC137526 |
| 基因名称 | LIN28B |
| Gene ID (NCBI) | 389421 |
| RRID | AB_2879403 |
| 偶联类型 | Unconjugated |
| 形式 | Liquid |
| 纯化方式 | Antigen affinity purification |
| UNIPROT ID | Q6ZN17 |
| 储存缓冲液 | PBS with 0.02% sodium azide and 50% glycerol, pH 7.3. |
| 储存条件 | Store at -20°C. Stable for one year after shipment. Aliquoting is unnecessary for -20oC storage. |
背景介绍
LIN28B, also named as CSDD2, belongs to the lin-28 family. It acts as a suppressor of microRNA (miRNA) biogenesis by specifically binding the precursor let-7 (pre-let-7). LIN2B is specifically expressed in embryonic muscle, neurons, and epithelia, as well as in embryonic carcinoma cells. However, it is suppressed in most adult tissues except for skeletal and cardiac muscle. The calculated molecular weight of LIN28B is 27 kDa, but a 35 kDa band has been detected in some articles (PMID: 33029224, 33378003).
实验方案
| Product Specific Protocols | |
|---|---|
| IF protocol for LIN28B antibody 24017-1-AP | Download protocol |
| IHC protocol for LIN28B antibody 24017-1-AP | Download protocol |
| IP protocol for LIN28B antibody 24017-1-AP | Download protocol |
| WB protocol for LIN28B antibody 24017-1-AP | Download protocol |
| Standard Protocols | |
|---|---|
| Click here to view our Standard Protocols |
发表文章
| Species | Application | Title |
|---|---|---|
Front Immunol Lin28 regulates thymic growth and involution and correlates with MHCII expression in thymic epithelial cells | ||
iScience Interactome analysis illustrates diverse gene regulatory processes associated with LIN28A in human iPS cell-derived neural progenitor cells | ||
Pharm Biol Peptides from the croceine croaker (Larimichthys crocea) swim bladder attenuate busulfan-induced oligoasthenospermia in mice. | ||
Cell Biol Toxicol The pivotal role of ZNF384: driving the malignant behavior of serous ovarian cancer cells via the LIN28B/UBD axis |